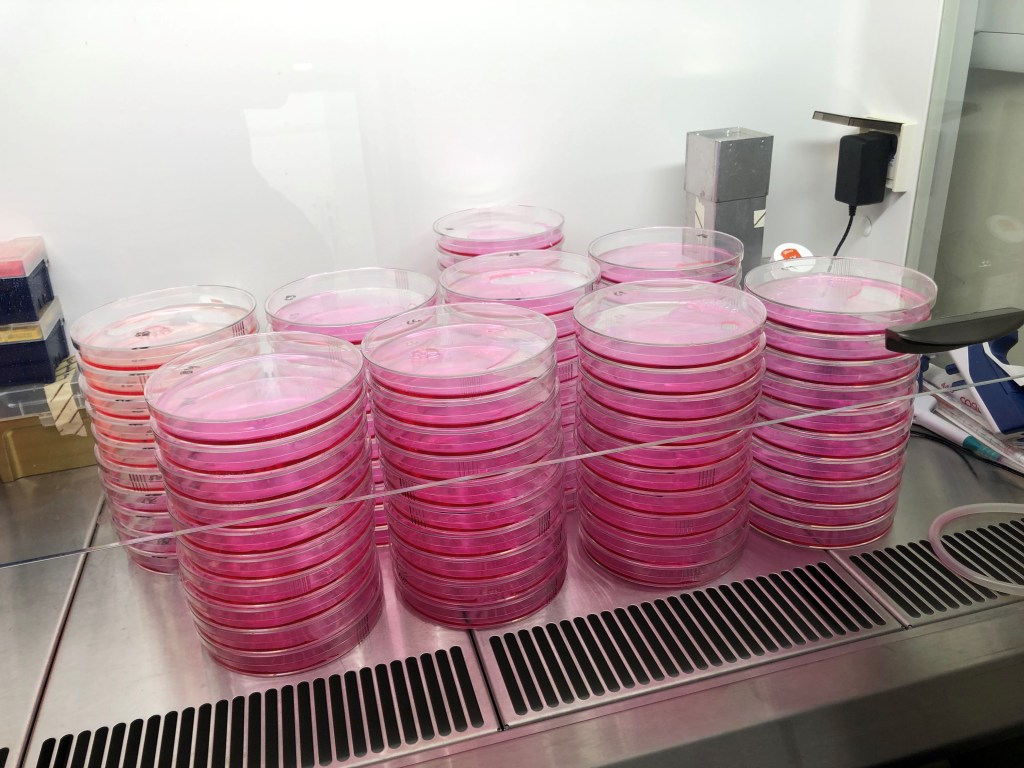

Alkuperäinen teksti (Original text): Päivi Pihlajamaa ja Alison Ollikainen
Suomennos: Päivi Pihlajamaa
Miksi syöpäsolut kasvavat nopeammin kuin normaalit solut? Mitkä mekanismit säätelevät kasvaimen kasvua? Onko niiden kasvua mahdollista hidastaa? Päivi Pihlajamaa, vanhempi tutkija Lääketieteellisen systeemibiologian tutkimusryhmästä, valottaa näitä kysymyksiä kertomalla tutkimusprojektistaan, jossa tutkitaan, mikä saa syöpäsolut kasvamaan terveitä soluja nopeammin, ja millainen rooli geenien säätelyverkostoilla on kasvaimen kasvun säätelyssä.
Voitko esitellä itsesi?
Olen biolääketieteen tutkija, ja teen kokeellista laboratoriotutkimusta. Koulutukseltani olen filosofian maisteri lääkekehityksen pääaineessa terveyden biotieteen koulutusohjelmasta (Turun yliopisto) ja filosofian tohtori Helsingin yliopiston lääketieteellisestä tiedekunnasta. Vuodesta 2014 olen työskennellyt post doc -tutkijana ja nykyisin vanhempana tutkijana Helsingin yliopistossa.
Missä työskentelet?
Työskentelen Helsingin yliopiston lääketieteellisessä tiedekunnassa professori Jussi Taipaleen johtamassa Lääketieteellisen systeemibiologian tutkimusryhmässä, joka kuuluu Suomen Akatemian Kasvaingenetiikan tutkimuksen huippuyksikköön. Olen myös työskennellyt vuoden professori Taipaleen ryhmässä Cambridgen yliopistossa Isossa-Britanniassa.
Mitä tutkimuksesi käsittelee?
Biolääketieteellinen perustutkimus on aina kiinnostanut minua, ja olen tutkinut transkriptiotekijöitä ja geenien säätelyä eri näkökulmista sekä väitöskirjatutkimuksessani että post-doc -vaiheen projekteissa. Tällä hetkellä päätavoitteeni on tutkia, mikä saa syöpäsolut kasvamaan terveitä soluja nopeammin.
Transkriptiotekijät ovat proteiineja, jotka sitoutuvat DNA:han säädellen sitä, mitkä geenit ilmentyvät kussakin solussa. Vaikuttavatko transkriptiotekijät myös kasvainten kasvuun?
Transkriptiotekijät säätelevät soluissa hyvin monia erilaisia toimintoja, mutta jotkin niistä, kuten MYC, säätelevät solujen kasvua. Normaalissa terveessä kudoksessa solujen kasvu ja jakautuminen ovat tarkasti säädeltyjä prosesseja. Kasvaimen kehittyessä solut onnistuvat välttämään kasvua jarruttavat säätelymekanismit ja voivat siten jakautua rajoittamattomasti. MYC transkriptiotekijän tiedetään toimivan yliaktiivisesti useammassa kuin joka toisessa ihmisen syövässä, joten sen toimintaa solukasvun säätelijänä on tärkeää tutkia.
Onko normaaleissa kudoksissa siis “tietty määrä” terveitä soluja, ja kasvaimissa liian paljon soluja, jotka myös kasvavat liian nopeasti?
Kyllä, kasvua normaalisti säätelevien mekanismien pettäminen johtaa siihen, että syöpäkasvaimissa solut jakautuvat jatkuvasti ja niiden määrä kasvaa siten liian suureksi. Omassa työssäni pyrin tunnistamaan täsmällisiä geenien säätelytapahtumia, joiden avulla transkriptiotekijät kuten MYC edistävät solujen kasvua ja jakautumista.
Miten solujen kasvun säätelyä tutkitaan?
Käytän tutkimuksessani laboratorio-oloissa kasvatettavia syöpäsoluja sekä uusimpia kokeellisia menetelmiä. Esimerkiksi CRISPR-Cas9 -menetelmällä, eli niin sanotuilla geenisaksilla, solujen genomiin voi tehdä pieniä ja tarkasti määriteltyjä muutoksia, joiden avulla pyrin osoittamaan tiettyjen geenien säätelytapahtumien yhteyden solujen kasvuun.
Kokeiden alussa teen solujen genomiin pieniä mutaatioita, joiden tarkoituksena on estää transkriptiotekijöiden, esimerkiksi MYC:n, sitoutuminen tiettyihin säätelyelementteihin. Tämän jälkeen kasvatan muokattuja soluja ja analysoin kunkin mutaation vaikutusta solujen kasvunopeuteen.

Kuinka monta mutaatiota teet soluihin?
Kokeissa voidaan tutkia joko muutamia mutaatioita tai jopa kymmeniä tuhansia mutaatioita kerralla. Kokeiden tulkinnan kannalta on kuitenkin tärkeää, että yksittäiseen soluun tehdään vain yksi mutaatio, koska silloin kunkin mutaation vaikutus solujen kasvuun on mahdollista erotella kokeen tuottamasta datasta.
Mistä tiedät, “minne” mutaatiot pitää tehdä?
Sekä meidän että muiden tutkimusryhmien aiempien tulosten perusteella voimme määritellä joukon geenejä, joiden ilmentymistasoa MYC todennäköisesti säätelee. Suunnittelen kokeissa tutkittavat mutaatiot siten, että ne estävät MYC:n sitoutumisen juuri näiden geenien säätelyelementteihin.
Jäljitteleekö tämä koeasetelma siis mutaatioita, joita havaitaan ihmisen kasvaimissa, ja johtavatko vastaavat mutaatiot kasvainten syntyyn?
Teoriassa samanlaisia mutaatioita voisi tapahtua myös ihmisen kasvaimissa, mutta paljon yleisemmin kasvaimissa havaitaan geneettisiä muutoksia, jotka johtavat MYC transkriptiotekijän yliaktiivisuuteen, mikä puolestaan lisää kasvua edistävien kohdegeenien ilmentymistä. Kokeessa tehtävien mutaatioiden ei siis ole tarkoitus jäljitellä ihmisen kasvaimissa havaittavia mutaatioita, vaan käytän niitä tutkimusvälineenä: jos tietty geeni tai säätelyelementti on tärkeä solujen kasvulle, sen muokkaaminen toimimattomaksi saa solut kasvamaan hitaammin.
Minkälaista tällainen laboratoriotyö käytännössä on, ja kauanko kokeet yleensä kestävät?
Mutaatioiden tekemisen jälkeen kasvatan soluja kokeissa ennalta määrätyn ajan, esimerkiksi viikon tai kolme viikkoa. Tämän jälkeen eristän solujen DNA:n, joka sekvensoidaan. Lopulta analysoin sekvenssidatasta, paljonko kutakin mutaatioita sisältäviä soluja lopullisesta solupopulaatiosta löytyy. Käytännössä kokeissa usein kasvatetaan satoja miljoonia soluja, jolloin käsittelen päivän aikana kymmeniä suuria soluviljelymaljoja.
Millaisia soluja käytät kokeissa ja mistä ne ovat peräisin? Voiko samanlaisia kokeita tehdä muidenkin kudosten soluilla?
MYC toimii yliaktiivisesti monissa ihmisen syöpätyypeissä, joten tämän tutkimuksen löydökset voivat aikanaan mahdollisesti auttaa monia syöpäpotilaita. Käytän kokeissani tällä hetkellä ihmisen paksusuolen syövän ja leukemian soluja, mutta muitakin solu- ja kudostyyppejä voi yhtä lailla käyttää samanlaisissa kokeissa.
Miten työsi voisi tulevaisuudessa auttaa syöpäpotilaiden hoitoa?
Koska MYC on solujen kasvun keskeinen säätelijä, se itsessään olisi ihanteellinen syöpälääkkeiden vaikutuskohde. Valitettavasti MYC:n toiminnan estämiseksi ei kuitenkaan ole saatavilla lääkkeitä. Siksi tässä projektissa yritämme tunnistaa, mitkä sen kohdegeeneistä ovat olennaisia solujen kasvulle muokkaamalla niiden säätelyalueilla olevia MYC:n sitoutumispaikkoja. Tavoitteena on löytää geenejä, joiden toimintaa olisi mahdollista estää lääkkeillä.
